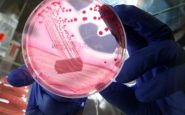
featured 2100236

Milano, 23 ott. (Adnkronos Salute) – "Grave epidemia di Escherichia coli", che si ritiene collegata ad alcuni ingredienti di un hamburger di McDonald's. I Centers for Disease Control and Prevention Usa riferiscono di 49 persone che in 10 stati hanno contratto lo stesso ceppo di E. coli, l'O157:H7, la maggior parte tra Colorado (27 casi) e Nebraska (9).
Dieci pazienti sono stati ricoverati in ospedale, un anziano è morto in Colorado, mentre un bambino è ricoverato con complicazioni da sindrome emolitico-uremica (Seu).
Tutti gli intervistati – si legge nell'alert lanciato dai Cdc – hanno riferito di avere mangiato al McDonald's prima che la malattia si manifestasse e la maggior parte ha detto di aver consumato un hamburger Quarter Pounder, che in Italia si chiama McRoyal DeLuxe.
L'ingrediente specifico associato all'infezione non è stato ancora identificato, ma l'indagine si sta concentrando su 2 ingredienti in particolare: cipolle fresche a fettine e polpette di manzo fresche.
McDonald's ha assicurato ai Cdc di avere rimosso in modo proattivo le cipolle a fettine e le polpette di manzo utilizzate per i Quarter Pounder dai negozi negli stati interessati, dove questo hamburger potrebbe risultare temporaneamente non disponibile.
Mentre le indagini proseguono, i Cdc rivolgono alcune raccomandazioni alla popolazione. In caso di gravi sintomi di infezione da E. coli dopo aver mangiato un hamburger Quarter Pounder da McDonald's, il consiglio è di cercare assistenza sanitaria e di informare il medico di cosa si è mangiato.
A quali sintomi fare attenzione? La maggior parte delle persone infettate da un batterio E. coli produttore di Shiga tossina avverte forti crampi allo stomaco, diarrea (spesso ematica, quindi con tracce di sangue) e vomito, descrive l'agenzia federale americana. In genere i disturbi cominciano 3 o 4 giorni dopo l'esposizione al batterio. La maggior parte degli infettati guarisce senza trattamento in 5-7 giorni, ma alcune persone potrebbero sviluppare gravi problemi renali come la Seu e potrebbero avere bisogno di un ricovero in ospedale.